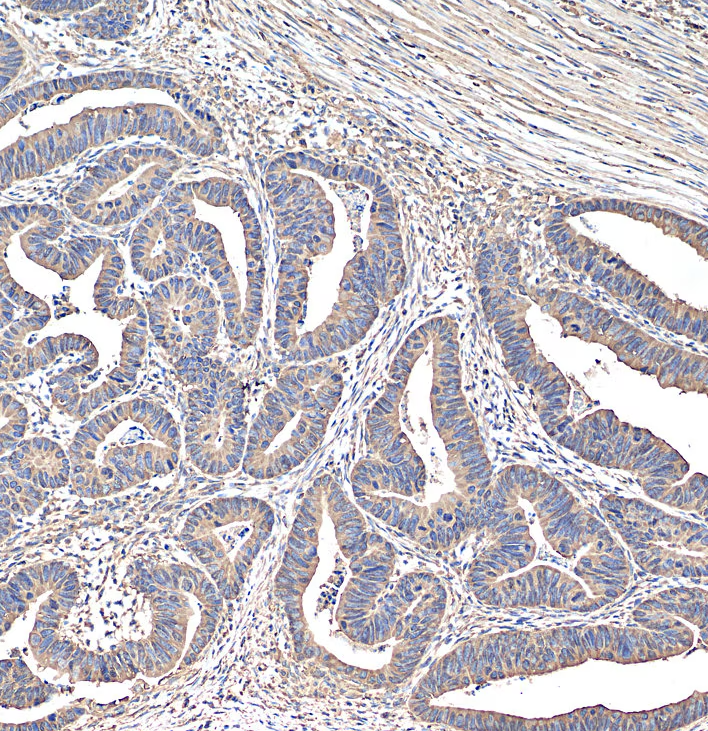

Alpha Tubulin Rabbit Polyclonal antibody
CAT.NO. : ARA6460
RMB Please choose
RMB Please choose
Size:
Trail, Bulk size or Custom requests Please contact us
Background
There are five tubulins in human cells: alpha, beta, gamma, delta, and epsilon. Tubulins are conserved across species. They form heterodimers, which multimerize to form a microtubule filament. An alpha and beta tubulin heterodimer is the basic structural unit of microtubules. The heterodimer does not come apart once formed. The alpha and beta tubulins, which are each about 55 kDa MW, are homologous but not identical. Alpha tubulin is useful for scientists across fields as an internal control due to its high, ubiquitous expression pattern.
Application
|
Application |
Dilution Ratio |
|
WB |
1:2000 - 1:50000 |
|
IP |
0.4-4.0 µg for 1.0-4.0 mg of total protein lysate |
|
IHC |
1:100 - 1:500 |
|
IF/ICC |
1:100 - 1:500 |
|
FC |
0.50 µg per 10^6 cells in a 100 µl suspension |
Overview
|
Reactivity |
Human, Mouse, Rat |
|
Host / Isotype |
Rabbit / IgG |
|
Class |
Polyclonal |
|
Type |
Antibody |
|
Immunogen |
Recombinant human Tubulin-Alpha protein |
|
Full Name |
tubulin, alpha 1b |
|
Calculated Molecular Weight |
50 kDa |
|
Observed Molecular Weight |
50-55 kDa |
|
GenBank Accession Number |
BC009314 |
|
Gene Symbol |
Alpha Tubulin |
|
Gene ID (NCBI) |
10376 |
|
Conjugate |
Unconjugated |
|
Form |
Liquid |
|
Purification Method |
Antigen affinity purification |
|
UNIPROT ID |
P68363 |
|
Storage Buffer |
PBS with 0.02% sodium azide and 50% glycerol, pH 7.3. |
Data

Various lysates were subjected to SDS PAGE followed by western blot with Alpha Tubulin Rabbit Polyclonal antibody at dilution of 1:10000 incubated at room temperature for 1.5 hours.

Immunohistochemical analysis of paraffin-embedded human colon cancer tissue slide using Alpha Tubulin Rabbit Polyclonal antibody at dilution of 1:200 (under 10x lens). Heat mediated antigen retrieval with Tris-EDTA buffer (pH 9.0).

Immunofluorescent analysis of (4% PFA) fixed HeLa cells using Alpha Tubulin Rabbit Polyclonal antibody at dilution of 1:200 and Fluor 488-Conjugated AffiniPure Goat Anti-Rabbit IgG(H+L), Fluor 594-Phalloidin (red).

IP result of Alpha Tubulin Rabbit Polyclonal antibody (IP:3ug; Detection:1:1000) with HeLa cells lysate 5000ug.

1x10^6 HEK-293 cells were intracellularly stained with 0.5 ug Alpha Tubulin Rabbit Polyclonal antibody and Fluor 488-Conjugated Goat Anti-Rabbit IgG(H+L) (red), or 0.5 ug rabbit IgG isotype control (blue). Cells were fixed with 4% PFA and permeabilized with Flow Cytometry Perm Buffer.
Storage
Store at +4℃ after thawing. Aliquot store at -20℃. Avoid repeated freeze / thaw cycles.
Research Use Only
For Research Use Only. Not for use in diagnostic procedures.
 New Products
New Products